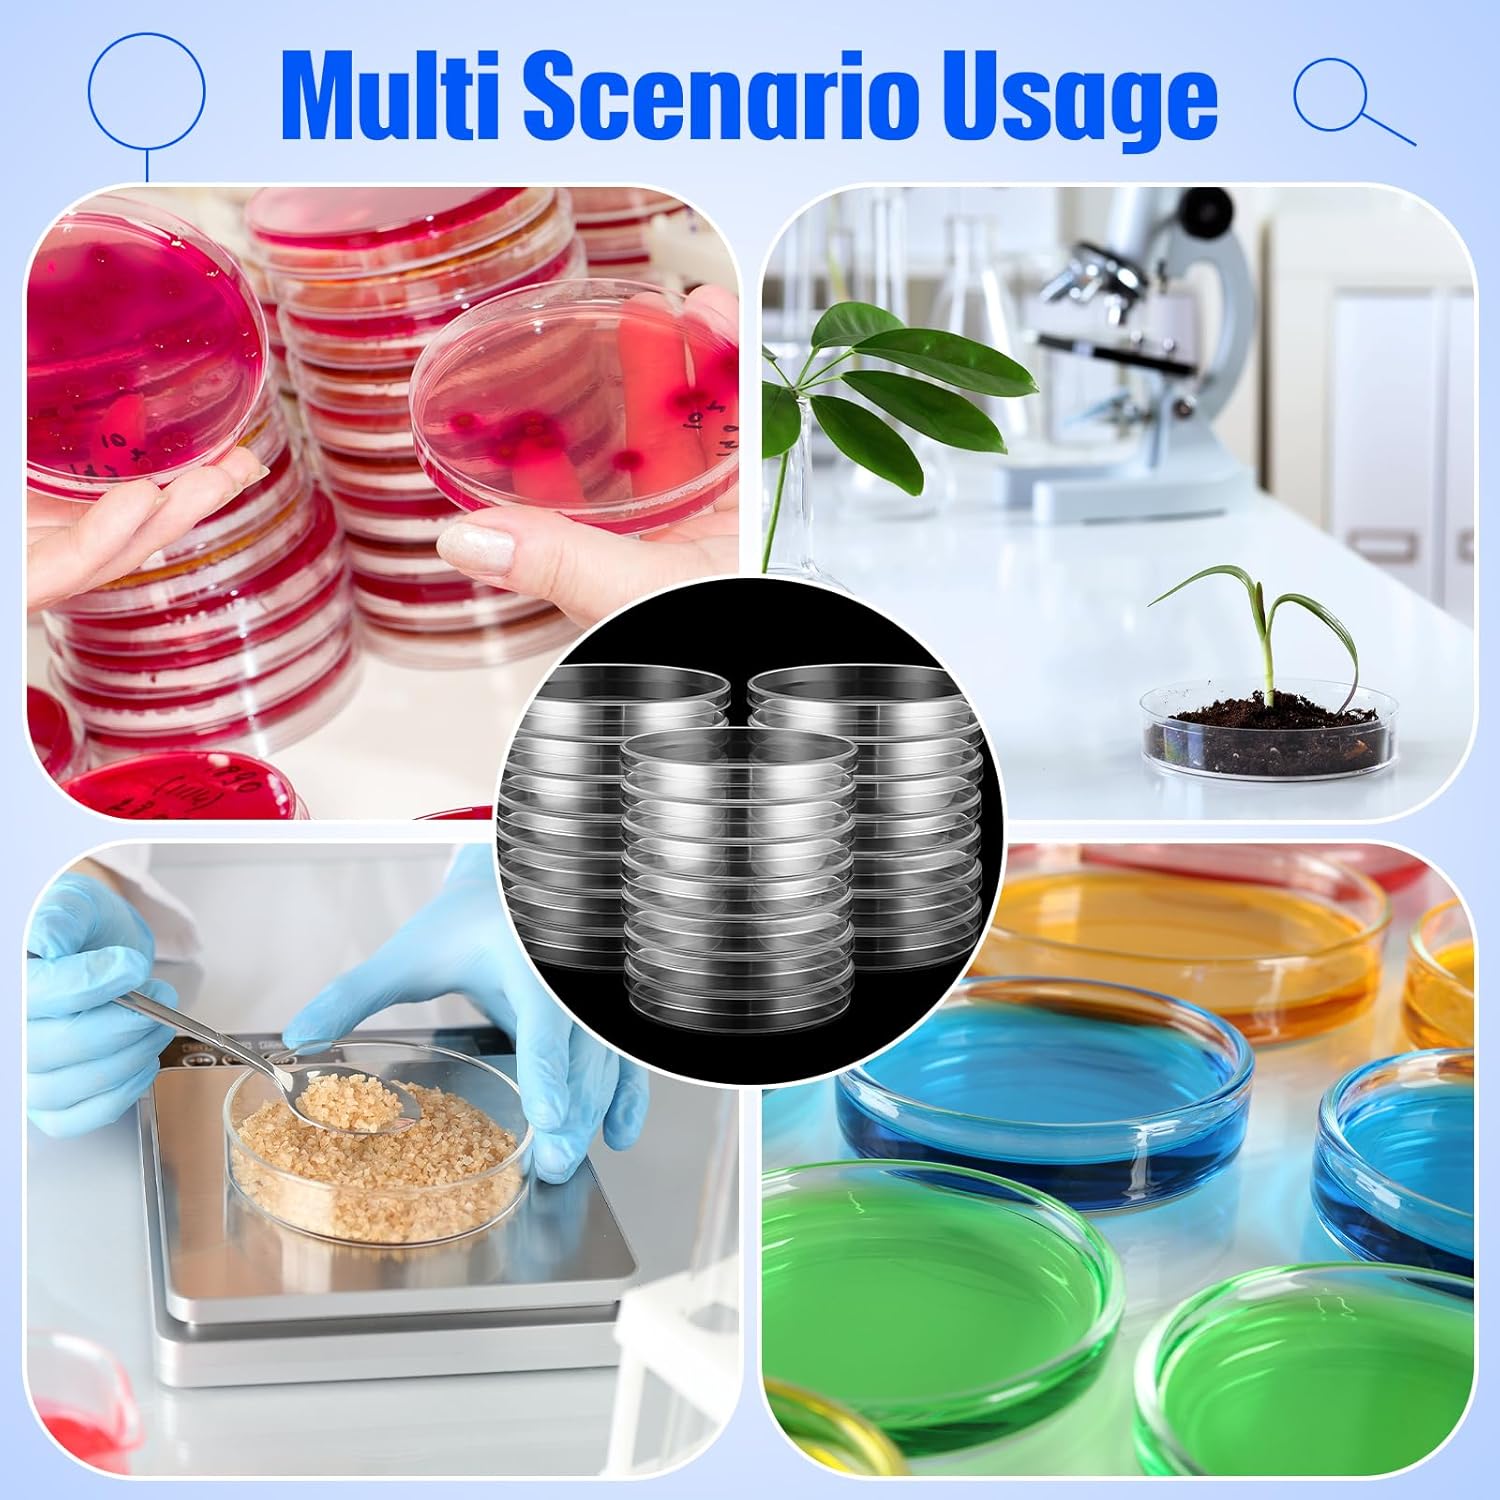

Giao hàng 24h
Với đơn hàng > 1.000.000 đ
- Chất liệu PS y tế cao cấp, độ trong suốt quang học tuyệt vời;
- Bề mặt đồng đều và nhẵn mịn, chắc chắn và khó hư hỏng;
- 3 lỗ thông hơi đúc trên nắp, cho phép trao đổi khí;
- Khử trùng bằng EO
Đĩa Petri 35mm, 60mm, 70mm, 90mm, 92mm, 100mm
Mã sản phẩm:
+ PD0035 (35*15mm)
+ PD0060 (60*15mm)
+ PD0070 (70*15mm)
+ PD0090 (90*15mm)
+ PD0092 (92*15mm)
+ PD0100 (100*15mm)
Chất liệu: PS
Đóng gói: 10 cái/túi tiệt trùng
Fcombio-USA
SX tại China
----------------
* Bề mặt đồng đều và nhẵn mịn, chắc chắn và khó hư hỏng;
* 3 lỗ thông hơi đúc trên nắp, cho phép trao đổi khí;

Đặc điểm:
- Chất liệu PS y tế cao cấp, độ trong suốt quang học tuyệt vời;
- Bề mặt đồng đều và nhẵn mịn, chắc chắn và khó hư hỏng;
- 3 lỗ thông hơi đúc trên nắp, cho phép trao đổi khí;
- Khử trùng bằng EO

===========
Petri dish 35mm, 60mm, 70mm, 90mm, 92mm, 100mm
Item No:
+ PD0035 (35*15mm)
+ PD0060 (60*15mm)
+ PD0070 (70*15mm)
+ PD0090 (90*15mm)
+ PD0092 (92*15mm)
+ PD0100 (100*15mm)
Material: PS
Packing: 10pcs/bag Sterile
Fcombio-USA
----------------
* Uniform and smooth surface, reliable and difficult to damage;
* 3 vents molded on lid, allowing for gas exchange;

Features:
- High grade medical PS material, excellent optical clarity;
- Uniform and smooth surface, reliable and difficult to damage;
- 3 vents molded on lid, allowing for gas exchange;
- EO sterilization
===========
#Petridishsquare #Petri_dish_square #petridishsquare #petri_dish_square
#Petridish #Petri_dish #petridish #petri_dish
#ĐĩaPetrivuông #Đĩa_Petri_vuông #diapetrivuong #dia_petri_vuong
#Đĩanuôicấy #Đĩa_nuôi_cấy #dianuoicay #dia_nuoi_cay
#PD0100C #pd0100c #PD0130C #pd0130c #PD0250C #pd0250c #Fcombio #fcombio
#Nuôicấytếbào #Nuôi_cấy_tế_bào #nuoicaytebao #nuoi_cay_te_bao
#phòngthínghiệm #phòng_thí_nghiệm #phongthinghiem #phong_thi_nghiem
===========
tekcovina
Nhập khẩu trực tiếp từ nhà sản xuất